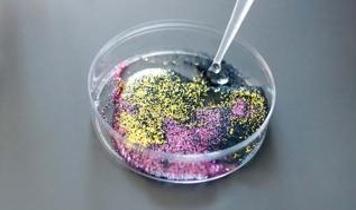
Bilim insanları itiraf etti! Mikroplastik ölçümlerinde büyük hata ortaya çıktı!

Fransa, Müslüman okulunu kapatıyor

Fransa Eğitim Bakanı Nicole Belloubet, Fransa'nın Nice kentindeki özel bir Müslüman okulunu finansal kaynaklarında belirsizlik olduğu gerekçesiyle kapatacaklarını bildirdi.
Le Point'ın haberine göre, Fransa'da Eğitim Bakanlığı, Alpes-Maritimes bölgesinin tek Müslüman okulu olan Nice'teki Avicenne Ortaokulunu kapatma kararı aldı.
France 2 televizyon kanalına konuşan Eğitim Bakanı Belloubet, "yapılan çok sayıda hatırlatmaya rağmen" kolejin finansal kaynaklarının net olarak bildirilmediğini ve bunun 2021 tarihli ayrılıkçılık karşıtı yasaya aykırı olduğunu ileri sürerek ortaokulu yeni eğitim döneminde kapatacaklarını söyledi.
- OKUL, BAKANLIĞIN KARARINA TEPKİLİ
Avicenne ortaokulu yönetiminden yapılan yazılı açıklamada, bakanlığın kapatma kararına tepki gösterildi.
Bakanlığın, okul yönetimine ve velilere haber vermeden bu kararını ulusal medyaya duyurduğu aktarılan açıklamada, okulun finansal durumunun açıldığı tarihten beri uzman bir muhasebeci tarafından takip edildiği vurgulandı.
Açıklamada, alınan kapatma kararının uygulanmaması için gerekenin yapılacağı kaydedildi.
- FRANSA'NIN İLK MÜSLÜMAN LİSESİNE DEVLET DESTEĞİ KESİLMİŞTİ
Aralık 2023'te Hauts-de-France Valisi Georges-François Leclerc, Lille kentinde bulunan ve üniversiteye yerleştirme başarısı yüzde 90'ın üstünde olan Özel Averroes Lisesi'nin "devletle sözleşmesinin iptal edilmesine karar vermişti.
Kararda, lisede verilen eğitimin "kaynak ve içerik" açısından Fransa Milli Eğitim Bakanlığı beklentilerinin "tamamını karşılamadığı" ileri sürülerek, okulun "Cumhuriyet değerlerine" uygun hareket etmediği iddia edilmişti.
Okul yönetimi bu kararı Danıştay'a taşıyacaklarını bildirmişti.
Okul, 2003'te eğitim hayatına başlamış, ilk olarak başörtülü olduğu için diğer eğitim kurumlarına gidemeyen Müslüman öğrencilere kapılarını açmıştı. Birkaç yılda öğrenci sayısını artıran lisenin yanı sıra 2012'de Averroes Ortaokulu da faaliyete başlamıştı.
- Popüler Haberler -

SON DAKİKA! Orta Doğu'da vakit daralıyor! Trump'tan "Zamanı geldi" çağrısı

Irak-Suriye hattında yeni dönem: 11 yılın ardından yeniden açıldı

İran'da kritik altyapı hedefte: Aynı köprü ikinci kez vuruldu

Orta Doğu için diplomasi trafiği: Putin ve Selman'dan küresel piyasaya uyarı

İran'dan ABD'nin kara saldırısı tehditlerine "Gelin bekliyoruz" yanıtı
Bilim insanları itiraf etti! Mikroplastik ölçümlerinde büyük hata ortaya çıktı!












